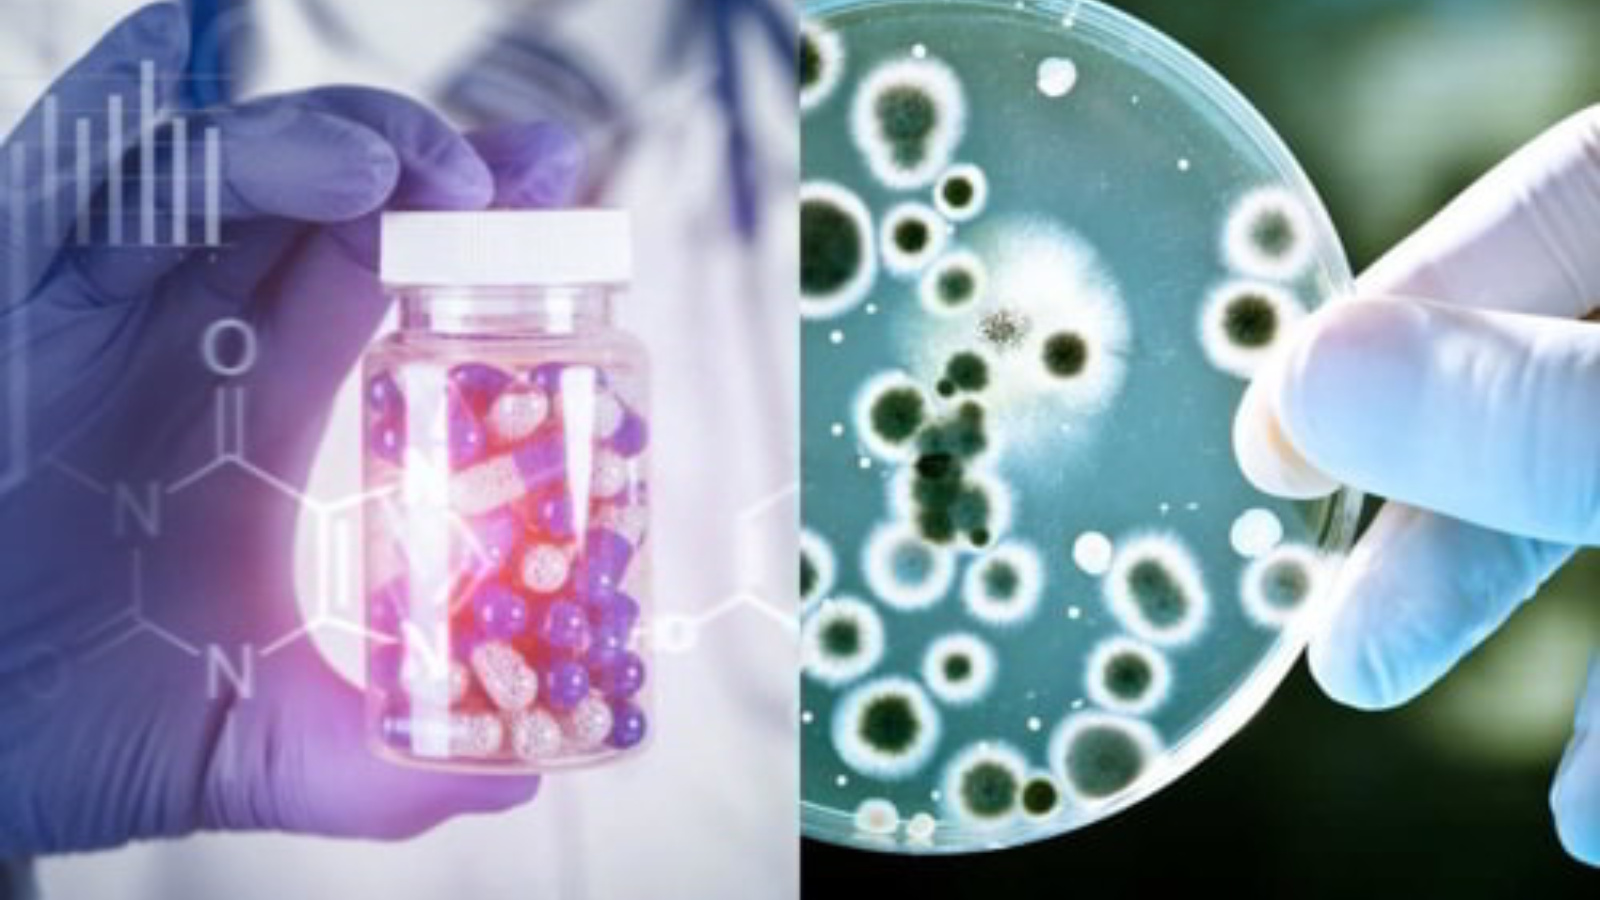

Если мы ничего не сделаем… Что будет через 20 лет? Сценарий "Тёмного будущего при развитии антибиотикорезистентности"
Антимикробная резистентность (АР) — одна из главных угроз современному здравоохранению и обществу. Если мы не сможем эффективно остановить рост устойчивости бактерий к антибиотикам, уже через 20 лет мир может оказаться перед лицом серьёзного «тёмного будущего». Что именно может произойти, если ничего не сделать?
Постоянно растущая угроза для здоровья
Сегодня антибиотики спасают миллионы жизней при инфекционных заболеваниях. Но бактерии умеют приспосабливаться: со временем они вырабатывают механизмы защиты от лекарств — антибиотикорезистентность. Если этот процесс не контролировать, обычные инфекции, которые сейчас легко лечатся, станут смертельными.
Через 20 лет:
Простуда, синусит и грипп могут чаще осложняться бактериальными инфекциями, которые невозможно будет вылечить.
Инфекции в больницах — после операций, при катетеризации или искусственной вентиляции легких — станут очень опасными.
Ежегодно будут умирать миллионы людей из-за неэффективности антибиотиков, что вернёт нас к эпохе до их открытия.
Медицинская помощь станет почти невозможной
Современная медицина напрямую зависит от антибиотиков. Без эффективных препаратов:
Хирургия превратится в лотерею: операции будут сопровождаться высоким риском смертельных осложнений.
Химиотерапия и трансплантация органов станут крайне опасными, поскольку из-за ослабленного иммунитета пациенты будут уязвимы к инфекциям.
Лечение туберкулёза, пневмонии, мочевых и кожных инфекций превратится в мучительный длительный процесс с низкой вероятностью успеха.
Социально-экономические последствия
Рост АР повлечёт огромные затраты на здравоохранение из-за длительных госпитализаций и новых, более дорогих препаратов. Производительность труда снизится из-за массовой болезни и преждевременной смертности. В странах с низким уровнем дохода ситуация будет особенно катастрофичной — там доступ к современным лекарствам и средствам диагностики уже ограничен.
Причины проблемы и сценарии развития
АР развивается под влиянием нескольких факторов:
Чрезмерное и неправильное использование антибиотиков в медицинской практике, ветеринарии и сельском хозяйстве.
Недостаток новых разработок антибиотиков — фармацевтическая отрасль в последние десятилетия снизила инвестиции в поиск новых препаратов.
Плохая гигиена, недостаток санитарии и отсутствие грамотного контроля инфекций особенно усиливают распространение устойчивых бактерий.
Если не принять меры, уже в 2045 году к предыдущим проблемам добавится полностью новая угроза — «супербактерии», которые не поддаются лечению никакими препаратами.
Что можно сделать прямо сейчас
Для избежания такого мрачного сценария существуют проверенные стратегии:
Сокращение и правильное использование антибиотиков только по назначению и под контролем врача.
Стимулирование разработки новых антибиотиков и альтернативных методов борьбы с инфекциями.
Улучшение гигиены в медучреждениях и повседневной жизни.
Образовательные программы для населения, врачей и фермеров о правильном использовании антибиотиков.
Единое глобальное взаимодействие и мониторинг для борьбы с устойчивостью.
Необходимо понимать — устойчивость антибиотиков не развивается сама по себе. Это результат наших действий и бездействия. Если не изменить подход к использованию антибактериальных средств, через 20 лет мы можем оказаться в мире, где простая инфекция вновь станет смертельной опасностью.
Ассистент кафедры микробиологии им. акад.
В.М. Аристовского Н.С. Чумарев
Зав.отделением ГВ и ПЗОЖ Г.Ф. Галимуллина